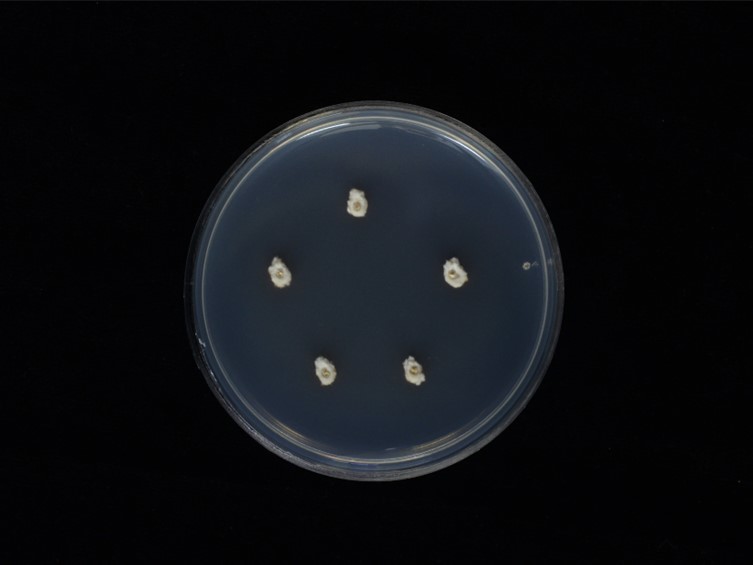

Holotype:
THAILAND, Phitsanulok Province, Ban Phaothai Community Forest, 4 Sep. 2016, K. Tasanathai, S. Mongkolsamrit, D. Thanakitpipattana, W. Noisripoom, R. Somnuk, P. Srikitikulchai, S. Wongkanoun, S. Lamlertthon, holotype BBH 42769, ex-type living culture BCC 82642.
Habitat:
Buried in the ground.
Host:
larva of Oxynopterus sp. (Coleoptera).
Description:
 Stromata two to eight, clavate, branched, up to 4 cm long, 2.5-3 mm wide. Rhizoids flexuous, arising from region between head and thorax of Coleoptera larva, up to 3 cm buried deep underground. Upper part of the stromata fertile, dark purple, 1-2.5 cm long, 2.5-5 mm wide.
Stromata two to eight, clavate, branched, up to 4 cm long, 2.5-3 mm wide. Rhizoids flexuous, arising from region between head and thorax of Coleoptera larva, up to 3 cm buried deep underground. Upper part of the stromata fertile, dark purple, 1-2.5 cm long, 2.5-5 mm wide.  Perithecia immersed, ordinal in arrangement with slightly protuberant ostiole, ovoid, 370-520 × 210-300 μm.
Perithecia immersed, ordinal in arrangement with slightly protuberant ostiole, ovoid, 370-520 × 210-300 μm.  Asci cylindrical, 8-spored, 150-250 × 5-8 μm, prominent apical cap, 5 × 5 μm.
Asci cylindrical, 8-spored, 150-250 × 5-8 μm, prominent apical cap, 5 × 5 μm.  Ascospores filiform, with septa but do not dissociate into part-spores, hyaline, 160-240 × 1.5-2 μm.
Ascospores filiform, with septa but do not dissociate into part-spores, hyaline, 160-240 × 1.5-2 μm.  Asexual morph seen in nature. Stipe erect, clavate, unbranched, flattened, covered with pale blue greenish to dark green mycelium covered by sporulating conidiophores. Terminal part of stroma purple. Conidiophores dense, consisting of 1-3
Asexual morph seen in nature. Stipe erect, clavate, unbranched, flattened, covered with pale blue greenish to dark green mycelium covered by sporulating conidiophores. Terminal part of stroma purple. Conidiophores dense, consisting of 1-3  phialides in whorls, nomuraea-like. Phialides cylindrical or subglobose and blunt at the ends, 5-10 × 3-3.5 μm.
phialides in whorls, nomuraea-like. Phialides cylindrical or subglobose and blunt at the ends, 5-10 × 3-3.5 μm.  Conidia cylindrical with rounded apices, 5-8 × 2-3 μm.
Conidia cylindrical with rounded apices, 5-8 × 2-3 μm.
Culture characteristics:
Colonies on PDA attaining a diam of 5 mm in 14 d, pale cream mycelium, fluffy, reverse colorless. Conidia and reproductive structures not observed.
Colonies on PDA attaining a diam of 5 mm in 14 d, pale cream mycelium, fluffy, reverse colorless. Conidia and reproductive structures not observed.
Reference:
Mongkolsamrit S, Khonsanit A, Thanakitpipattana D, et al. (2020). Revisiting Metarhizium and the description of new species from Thailand. Studies in Mycology 95: 171–251.
DOI: https://doi.org/10.1016/j.simyco.2020.04.001Species |
Strain |
Compound |
Pubchem CID |
Biological activity |
Reference |
|---|
|
Strain |
ITS | LSU | RPB1 | RPB2 | TEF1 |
|---|---|---|---|---|---|
| BCC 82173 | MN781919 | MN781866 | MN781768 | MN781815 | MN781722 |
| BCC 82642 | MN781918 | MN781867 | MN781769 | MN781816 | MN781723 |
| BCC 83548 | MN781920 | MN781868 | MN781770 | - | MN781724 |